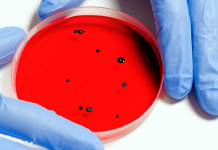
Monitoramento de vírus, fungos e bactérias poderá evitar novas pandemias

Talibã mata e exibe corpos de supostos sequestradores em cidade do Afeganistão
Situação ocorreu em Herat, no oeste do país; segundo extremistas, medida será comum contra os que não cumprirem as regras e servirá de aviso...
Passaporte da vacinação: como obter certificado que comprova imunização contra Covid
Certificado pode ser obtido em app do Ministério da Saúde; caderneta de vacina e documento de secretarias estaduais e municipais também podem ser usados...
Espanha fecha aeroporto por causa de cinzas do vulcão Cumbre Vieja
Erupção cresceu com duas novas bocas de lava e obrigou retirada de pessoas; 6.200 moradores e 420 construções já foram afetados.
O aeroporto da ilha...
Preço médio da gasolina sobe pela 8ª semana seguida nos postos, mostra ANP
Valor segue acima de R$ 6 por litro. Pesquisa também mostra alta nos valores do etanol e leve recuo no óleo diesel.
O preço médio...
Cadelinha que viralizou ao ‘acenar’ para clientes foi resgatada à beira da morte e...
Morador de Catanduva/SP, Jeferson Alexandre Rodrigues, de 53 anos, contou que a cadelinha aprendeu a levantar a pata para ganhar carinho. 'Ela recebe todo...
Monitoramento de vírus, fungos e bactérias poderá evitar novas pandemias
Especialistas alertam para os desafios de diagnosticar e combater patógenos emergentes e integrar governos para evitar surtos de doenças.
A pandemia de COVID-19 tornou mais...
Exposição excessiva de crianças em redes sociais pode causar danos
Pediatras alertam para os perigos desse hábito, o sharenting.
A menina Alice, de 5 anos, ama tirar fotos e vídeos. Ela tem um perfil na...
Caixa paga hoje auxílio emergencial a nascidos em maio
Benefício varia de R$ 150 a R$ 375, dependendo da família.
Trabalhadores informais nascidos em maio recebem hoje (25) a sexta parcela da nova rodada...
Talibã diz que voltará a aplicar amputação de mão como pena
Chefe do grupo extremista afirma que esse tipo de punição para criminosos é necessário para a segurança do Afeganistão.
Um dos mais influentes líderes do...
Votuporanga registra mais 6 casos de Covid-19
De acordo com o boletim epidemiológico, 8 pacientes estão hospitalizados, sendo 3 em UTI (Unidade de Terapia Intensiva). Município contabiliza 447 mortes causadas pelo...